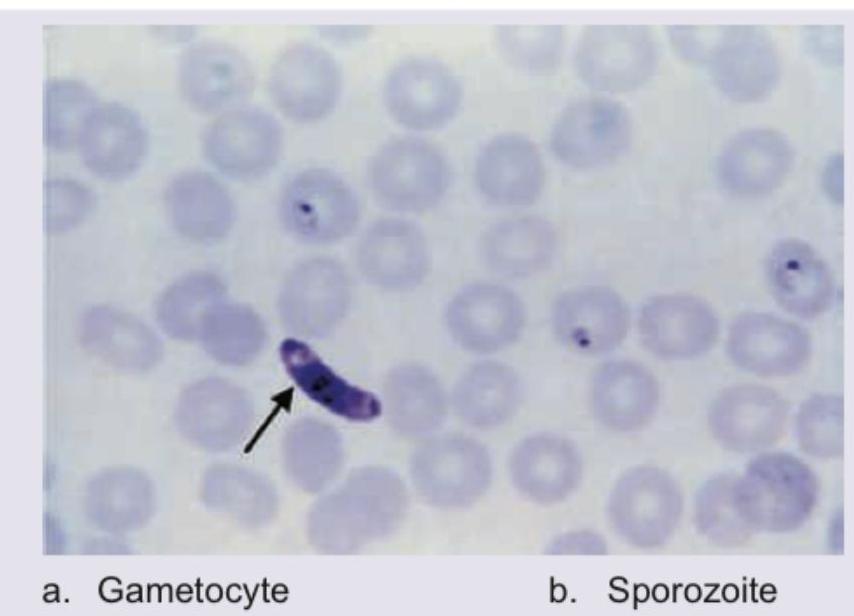
Image for question 780

Which among the following parasites directly invade the skin?
Choose the organisms that have two morphological forms: 1. Acanthamoeba 2. Naegleria 3. Giardia 4. Trichomonas
A child presents with anal pruritus. Microscopy of the stool sample reveals a plano-convex egg. Identify the pathogen.
Which of the following parasites is capable of causing autoinfection leading to hyperinfection syndrome?
A middle-aged man from an endemic region presents with progressive swelling of the lower limb. A peripheral blood smear shows the following structure. What is the most likely cause of his limb swelling?
A 5-year-old child presents with nocturnal perianal itching. The image below shows the organism identified on an adhesive tape test. What is the most likely causative agent?
The given image shows:

The larva shown belongs to which mosquito?

The following diagram depicts blood smear of which species?

A 20-year-old lady presents with high grade fever and incoherent talking for 1 day. The following peripheral smear shows presence of:
Explanation: ***Schistosoma mansoni***- The infectious stage, the **cercariae**, actively penetrate the intact skin of the human host when swimming or wading in contaminated water. - This stage bypasses the need for an insect vector and directly initiates infection, often causing **'swimmer's itch'** at the site of entry.*Dracunculus medinensis*- This infection is acquired by the oral route through ingestion of **copepods** (water fleas) containing the larval stage in drinking water.- While the mature female worm creates a painful **blister** to exit the skin, it does not invade the skin to initiate the infection.*Wuchereria bancrofti*- This parasite is transmitted by the bite of an **infected mosquito** (e.g., *Culex*), which deposits infective larvae near the bite site.- The larvae enter the host through the **puncture wound** created by the mosquito bite, not by actively penetrating intact dermal layers.*Onchocerca volvulus*- The transmission involves the bite of an infected **blackfly** (*Simulium* species), which transmits the infective larvae (microfilariae) into the host.- The larvae enter through the **wound site** created by the fly bite and subsequent manipulation of the wound by the vector (not direct skin invasion).
Explanation: ***1, 3 are correct*** - **Acanthamoeba** has exactly **two morphological forms**: the **trophozoite** (active, feeding form) and the **cyst** (dormant, resistant form). The cyst form allows survival in adverse environmental conditions. - **Giardia lamblia** also has exactly **two forms**: the **trophozoite** (flagellated, binucleate form that colonizes the small intestine) and the **cyst** (quadrinucleate, infectious form passed in feces). - Both organisms strictly exhibit a **two-stage life cycle** with trophozoite and cyst stages only. *Incorrect: 1, 2 are correct* - While **Acanthamoeba** does have two forms, **Naegleria fowleri** has **THREE morphological forms**: amoeboid trophozoite, temporary flagellate form, and cyst. - The flagellate form of Naegleria is a distinctive third morphological stage that appears under certain environmental conditions (e.g., distilled water). - Therefore, Naegleria does **not** meet the criteria of having exactly two forms. *Incorrect: 1, 2, 3, 4 are correct* - **Trichomonas vaginalis** exists **only as a trophozoite** and has **no cyst stage**, making it a single-form organism. - The absence of a cyst form in Trichomonas explains why it requires direct transmission (sexual contact) and cannot survive long outside the host. - This option incorrectly includes both Naegleria (three forms) and Trichomonas (one form). *Incorrect: 1, 4 are correct* - **Trichomonas vaginalis** lacks a cyst stage entirely, existing only as a motile trophozoite with four anterior flagella and an undulating membrane. - This makes Trichomonas unsuitable for the answer as it does not have two morphological forms.
Explanation: ***Enterobius*** - **_Enterobius vermicularis_** (pinworm) is the classic cause of **perianal pruritus** (anal itching), especially at night, which is a hallmark symptom in children. - The eggs are characteristically **plano-convex** (flattened on one side) or D-shaped, matching the description in the question. Diagnosis is typically confirmed with the **Graham sticky tape test**. ***Trichuris*** - The eggs of **_Trichuris trichiura_** (whipworm) are **barrel-shaped** with prominent **polar plugs** at each end, which does not match the description. - Heavy infections can lead to **rectal prolapse**, abdominal pain, and dysentery, but not typically isolated anal pruritus. ***Ascaris*** - **_Ascaris lumbricoides_** eggs are either corticated (with a bumpy, mamillated outer layer) or decorticated (smooth), but they are round-to-oval, not plano-convex. - Clinical features include **pneumonitis** during larval migration (**Loeffler's syndrome**) and potential **intestinal or biliary obstruction** in heavy infections. ***Ancylostoma*** - The eggs of **_Ancylostoma duodenale_** (hookworm) are oval with a thin, smooth shell, containing a developing embryo (blastomeres), which is morphologically distinct. - Hookworm infection is a major cause of **iron deficiency anemia** due to chronic blood loss from the intestine.
Explanation: ***Strongyloides stercoralis*** - This parasite is unique among helminths for its ability to cause **autoinfection with hyperinfection syndrome**, a potentially life-threatening condition. - The **rhabditiform larvae** can accelerate development directly into invasive **filariform larvae** within the host's large intestine. - This transformation allows the infectious filariform larvae to penetrate the intestinal mucosa or perianal skin, leading to persistent infection and potentially fatal **hyperinfection syndrome** in immunocompromised hosts. - This makes *S. stercoralis* the most clinically significant parasite causing autoinfection. *Incorrect: Ancylostoma duodenale* - This hookworm does not cause autoinfection, as its eggs must exit the host and mature in the soil to form infectious **filariform larvae**. - Infection occurs through **percutaneous penetration** (skin penetration) by larvae from the external environment. *Incorrect: Ascaris lumbricoides* - This large roundworm requires an environmental phase where unembryonated eggs mature in the soil before becoming infectious upon ingestion (**fecal-oral route**). - Its life cycle involves migration through the lungs (pulmonary phase), but it lacks the mechanism for internal autoinfection. *Incorrect: Hymenolepis nana* - *H. nana* (dwarf tapeworm) is capable of internal autoinfection where eggs hatch within the intestinal lumen and **oncospheres** invade the villi directly. - However, it does **not** cause hyperinfection syndrome like *S. stercoralis*, making it clinically less significant in this context. - The question specifically asks about autoinfection leading to hyperinfection syndrome, which is unique to *Strongyloides stercoralis*.
Explanation: ***Lymphatic obstruction*** - The image displays **microfilariae** (suggesting **Lymphatic Filariasis**), where the adult worms settle in the lymphatics, physically blocking flow. - This obstruction results in chronic, progressive edema (known as **lymphedema** or **elephantiasis**) due to the failure of lymphatic drainage in the affected limb. *Hypoalbuminemia* - Edema from **hypoalbuminemia** is due to low plasma oncotic pressure and typically results in generalized, pitting edema, which is not characteristic of chronic, localized filarial swelling. - While malnutrition might co-exist, the core pathology shown by the presence of **microfilariae** points specifically to mechanical lymphatic blockage. *Hypoproteinemia* - **Hypoproteinemia** is a general cause of edema via reduced **oncotic pressure**, leading to fluid shift into the interstitial spaces, usually causing generalized rather than localized swelling. - This systemic cause does not account for the specific parasitic damage to the lymphatics demonstrated by the presence of the **filarial worms**. *increased hydrostatic pressure* - Increased hydrostatic pressure (e.g., in conditions like DVT or CHF) leads to fluid leakage from capillaries, causing pitting edema. - The root cause here is the parasitic **destruction and obstruction of lymph nodes and channels**, which specifically impairs lymph return, not capillary hydrostatic pressure regulation.
Explanation: ***Enterobius vermicularis*** - The clinical presentation of **nocturnal perianal itching** (pruritus ani) in a child is highly characteristic of **pinworm infection** (enterobiasis). - The image shows a classic **D-shaped** or planoconvex egg, frequently found on the **adhesive tape test**, which are key identifiers for *Enterobius vermicularis*. *Ancylostoma duodenale* - This parasite causes **hookworm disease**, typically manifesting as **iron-deficiency anemia** and rarely perianal itching. - *Ancylostoma* eggs are oval, thin-shelled, and typically found in the **stool**, not via a tape test. *Hymenolepis nana* - This is the **dwarf tapeworm**, which usually causes mild or asymptomatic infection, though heavy infections can cause abdominal discomfort. - The eggs are small, oval, and possess **polar filaments** between the shell and the oncosphere, which are absent in the image. *Trichuris trichiura* - This parasite, the **whipworm**, causes trichuriasis, which presents with bloody diarrhea and occasionally **rectal prolapse** in heavy infections. - *Trichuris* eggs are distinctively **barrel-shaped** with two prominent bipolar mucoid plugs at each end.
Explanation: ***Spaghetti plot*** - A **spaghetti plot** is characterized by multiple lines, each representing an individual's data trajectory over time or across a continuum, hence resembling strands of spaghetti. - The image displays two distinct data distributions (Left-skewed and Right-skewed) with individual lines indicating the **mean, median, and mode** for each, which is a common feature in spaghetti plots when illustrating how different statistical measures behave in skewed distributions. *Kaplan Meier plot* - A Kaplan-Meier plot is a **survival curve** that estimates the probability of survival over time following a treatment or diagnosis. - It consists of **step-like decreases** indicating events (e.g., death, recurrence) and does not show measures of central tendency like mean, median, and mode as depicted in the given image. *Funnel plot* - A funnel plot is used primarily in **meta-analyses** to assess publication bias or **heterogeneity** among studies. - It typically displays effect sizes of individual studies against a measure of their precision (e.g., standard error), forming a **symmetrical funnel shape** if no bias is present. *Forest plot* - A forest plot is used in **meta-analyses** to graphically present the results of individual studies and their combined (pooled) effect. - It features **squares or diamonds** representing effect estimates and **horizontal lines** representing confidence intervals for each study and the overall summary effect.
Explanation: ***Anopheles*** - The larva is characterized by its **orientation parallel to the water surface**, due to the absence of a long breathing siphon. - Presence of **palmate hairs** on the thorax and abdomen helps in flotation at the water surface. *Culex* - The larva of *Culex* mosquitoes typically has a **long, slender breathing siphon** and hangs downwards from the water surface at an angle. - It does not possess the prominent palmate hairs seen in *Anopheles* for surface flotation. *Mansonia* - *Mansonia* larvae are unique because they have a **modified siphon adapted for piercing aquatic plant stems** to obtain oxygen, rather than breathing directly from the surface. - Consequently, they are typically found attached to submerged vegetation and do not float at the water surface. *Aedes* - Similar to *Culex*, *Aedes* larvae possess a **siphon for breathing**, causing them to hang downward from the water surface. - However, the siphon of *Aedes* is generally **shorter and stouter** than that of *Culex*, and they also lack palmate hairs for surface flotation.
Explanation: ***Plasmodium falciparum*** - The image displays characteristic **crescent-shaped or banana-shaped gametocytes** (stages 16-20), which are **pathognomonic for *Plasmodium falciparum*** - The earlier stages (1-5) represent ring forms (multiple rings per RBC, delicate ring forms) - Subsequent stages (6-15) show maturation culminating in the distinct **crescentic gametocytes** - This morphology is the **key distinguishing feature** of P. falciparum *Plasmodium vivax* - Produces **oval-shaped gametocytes**, not crescent-shaped - Characterized by enlarged RBCs with **Schüffner's dots** - Shows amoeboid trophozoites, not seen in this smear *Plasmodium malariae* - Produces **oval to round gametocytes** - Characteristic **band forms** and **rosette-shaped schizonts** (8-12 merozoites) - Not crescent-shaped as shown in the image *Plasmodium ovale* - Produces **oval gametocytes** similar to P. vivax - RBCs show **fimbriated edges** and Schüffner's dots - Does not produce crescent-shaped gametocytes
Explanation: ***Gametocyte*** - The image clearly shows a **crescent-shaped** parasite within a red blood cell, which is characteristic of the **gametocytes of *Plasmodium falciparum***. - The patient's symptoms of **high-grade fever** and **non-coherent talking** (suggesting cerebral malaria) are consistent with severe *P. falciparum* infection, where gametocytes are often seen on peripheral smears. *Sporozoite* - Sporozoites are the **infectious forms of malaria parasites** transmitted from the mosquito to humans; they are typically found in the **salivary glands of mosquitoes** and briefly in human blood before infecting liver cells. - They are generally **not observed in peripheral blood smears** during the symptomatic phase of malaria. *Merozoite* - Merozoites are the forms that emerge from **infected liver cells** and then subsequently from **infected red blood cells** to invade new red blood cells, thus perpetuating the asexual cycle. - They are very **short-lived extracellularly** and are rarely seen in peripheral blood smears; instead, **ring forms, trophozoites, and schizonts** (representing asexual stages) are typically observed inside red blood cells. *Schistocyte* - Schistocytes are **fragmented red blood cells** that result from **mechanical damage** to red blood cells, often seen in conditions like microangiopathic hemolytic anemia or disseminated intravascular coagulation. - They are not a life stage of the malaria parasite; their presence would indicate a co-existing or secondary hematological issue, not a parasitic form.
Classification of Parasites
Practice Questions
Intestinal Protozoa
Practice Questions
Blood and Tissue Protozoa
Practice Questions
Malaria Parasites
Practice Questions
Leishmaniasis
Practice Questions
Intestinal Helminths: Nematodes
Practice Questions
Tissue Nematodes
Practice Questions
Trematodes
Practice Questions
Cestodes
Practice Questions
Ectoparasites
Practice Questions
Antiparasitic Drugs
Practice Questions
Laboratory Diagnosis of Parasitic Infections
Practice Questions
Get full access to all questions, explanations, and performance tracking.
Start For Free